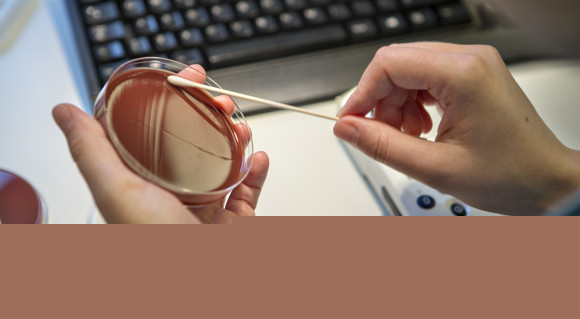

Vidensområder
VIVEs viden på velfærdsområdet er samlet i otte indgange. Hvert vidensområde har oversigter over udgivelser, eksperter, igangværende undersøgelser og arrangementer samt link til temaer og større projektforløb.
I fokus
Undersøgelse i gang
VIVE opstiller scenarier for, hvordan de mest effektive digitale sundhedsløsninger kan udpeges
Digitale sundhedsløsninger skaber nye muligheder for behandling af patienter, men stiller samtidig sundhedsvæsenet over for opgaven med at udpege og implementere de mest effektive løsninger.


















